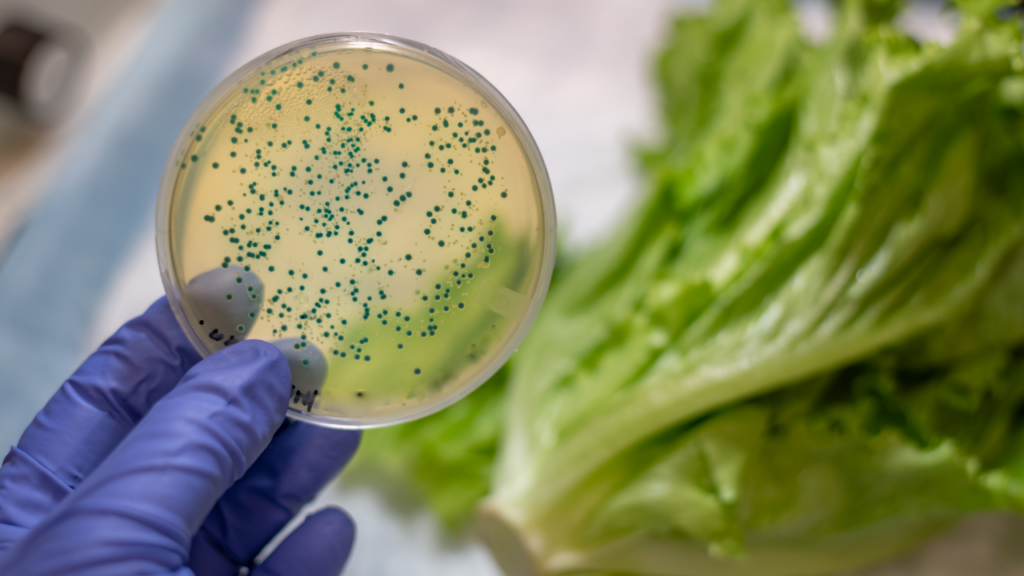

Supermercados e Lojas de Fast Fashion são os mais Sensíveis a Mudanças de Preço

Um estudo recente do Ibevar publicado pela revista Mercado&Consumo revelou que a preocupação com o preço varia bastante entre os diferentes segmentos do varejo brasileiro. Supermercados, fast fashion e roupas esportivas lideram a lista com a maior sensibilidade, atingindo a pontuação máxima de 8 em uma escala de 0 a 10. Isso significa que os […]
Checkout RH marca presença na ABRAS’24 Food Retail Future

Estreante no evento, oportunidade foi importante para apresentar o programa de estágio para supermercadistas de todo o país Um dos eventos de maior prestígio do setor supermercadista contou, pela primeira vez, com a participação da Checkout RH: a Abras’24 Food Retail Future. Realizado em Campinas, entre os dias 15 e 17 de setembro, o encontrou […]
Governo Eleva Estimativa de Salário Mínimo para R$ 1.509 em 2025

A pressão inflacionária dos últimos meses, aliada à necessidade de recuperar o poder de compra dos trabalhadores, impulsionou uma revisão significativa na estimativa do salário mínimo para 2025. Atualmente, o valor em discussão é de R$ 1.509, o que representaria um aumento de 6,87% em relação ao valor vigente atual, que é de R$ 1.412 […]
6 em cada 10 Brasileiros já se Preparam para a Black Friday

Novembro é mês de grandes promoções no varejo com a Black Friday, data no calendário cada vez mais consolidada no Brasil. Mas a preparação do shopper para esta data começa meses antes. É o que mostra uma pesquisa inédita realizada pela Globo. Cerca de 50% dos entrevistados iniciam as buscas com 1 mês ou mais […]
Bebidas Funcionais: Muito Além da Hidratação

As chamadas bebidas funcionais vêm conquistando cada vez mais espaço na rotina dos brasileiros. Muito mais do que simples bebidas, elas prometem benefícios à saúde que vão além da hidratação básica. Sua formulação especial, rica em vitaminas, minerais, fibras, probióticos e proteínas, oferece um verdadeiro arsenal para o nosso organismo. Ao consumir este tipo de […]
Mercado Pet Brasileiro em Alta

O mercado pet brasileiro demonstra um crescimento constante, impulsionado pela humanização dos animais de estimação e pelo aumento do número de cães e gatos nos lares brasileiros, que já ultrapassa 54 milhões de animais. Em 2023, o setor, segundo o IPB (Instituto Pet Brasil), faturou expressivos R$ 67,4 bilhões, consolidando o país como um dos […]
Tendências Grab and Go

Por William Saab Para pegar, levar e se apaixonar Os pontos “grab and go” no varejo alimentar conquistam cada vez mais fãs. Mostramos porque este formato de alimentação tem feito sucesso para quem não abre mão de pratos gostosos, saudáveis e práticos. Imagine um local onde você encontra refeições prontas, frescas, saborosas e embaladas para […]
Para Fazer Diferença nas Vendas de Fim de Ano

Por William Saab O mercado está acirrado, por isso, é preciso criar diferenciações para se destacar na época mais lucrativa do varejo Em um mercado altamente competitivo, captar a atenção do consumidor exige mais do que apenas uma boa oferta. Alguns recursos se mantêm infalíveis como se comunicar de forma clara, concisa e impactante, demonstrando […]
Entenda os Principais Índices de Preços: IPA, IPC e INCC

por Igor Francisco Ferramentas essenciais para acompanhar a variação dos preços de bens e serviços ao longo do tempo, tais índices precisam ser observados e compreendidos por quem pretende atuar estrategicamente no varejo A economia pode parecer um assunto complexo, mas ela afeta diretamente a vida de cada um de nós e também a das […]
Contaminação Cruzada – Boas Práticas de Higiene e Limpeza Garantem Alimentação Segura aos Clientes
Por William Saab Perigo invisível A contaminação cruzada representa um risco para a saúde. Saiba como seu supermercado pode reduzir as chances dela aparecer Por mais cuidadoso e higiênico que um supermercado possa ser, existem riscos invisíveis e que somente um protocolo sanitário em dia é capaz de eliminá-los. Isto envolve o treinamento de colaboradores, […]
